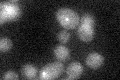
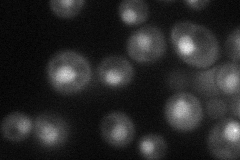
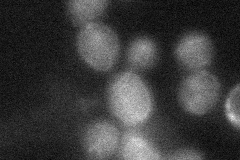
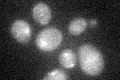

View description
Endonuclease involved in processing DNA during recombination and repair; cleaves branched structures in a complex with Slx1p; involved in Rad1p/Rad10p-dependent removal of 3'-nonhomologous tails during DSBR via single-strand annealing
Localization:
Intensity:
Fold change:
Significance:
-
C’ GFP library in SD
nucleus17.97 -
N' NOP1pr-GFP in SD
punctate,nucleus37.0127 -
N' TEF2pr-mCherry in SD

punctate,nucleus109.554 -
N' NATIVEpr-GFP in SD

punctate22.4911 -
N' TEF2pr-VC and Cyto-VN in SD
cytosol26.8903 -
C’ GFP library in SD+DTT

nucleus19.091.06No -
C’ GFP library in SD+H2O2
nucleus20.761.15No -
C’ GFP library in Starvation Media

nucleus16.580.92No -
C’ GFP library on the background of Pup2-DaMP

nucleus -
C’ GFP library on the background of CCT mutant

nucleus18.84591.04822No
